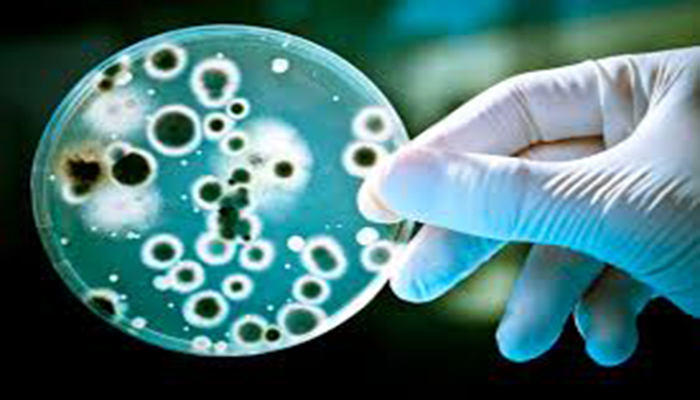

Berita Kesehatan
Ngeri, 5 Benda di Rumahmu Ini Ternyata Jadi Sarang Kuman Penyakit
Ngeri, 5 benda di rumahmu ini ternyata jadi sarang kuman penyakit yang bisa membahayakan kesehatanmu.
Penulis: OMDSMY Novemy Leo | Editor: OMDSMY Novemy Leo
POS-KUPANG.COM - Ngeri, 5 benda di rumahmu ini ternyata jadi sarang kuman penyakit yang bisa membahayakan kesehatanmu.
Tempat yang kotor tentu menjadi area yang sangat disukai oleh kuman, selain itu juga bisa merusak pandangan mata.
Namun, tahukah kamu di dalam rumah terdapat beberapa benda yang bisa menjadi sarang berkumpulnya kuman sumber penyakit?
Benda-benda dalam rumah bisa jadi pemicu bakteri bila jarang dibersihkan, hal ini bisa mengganggu kesehatan anggota keluarga.
Baca: Ramalan Zodiak Hari Ini, Rabu 1 Agustus 2018, Leo Bijak, Libra Tetap Fokus
Baca: 5 Zodiak Diprediksi Beruntung Pada Minggu Pertama Bulan Agustus 2018, Apakah Kamu Termasuk?
Dilansir Grid.ID dari Health24, ini dia benda yang wajib dibersihkan untuk mencegah munculnya bakteri dan kuman.
1. Pakaian
Setelah digunakan, pakaian harus dicuci agar tetap bersih, karena pakian bekas bisa menimbulkan bau keringat dan debu juga menempel.
Apalagi pakaian dalam, harus dicuci setiap hari agar tak berbagaya bagi organ intim saat dipakai lagi.
2. Toilet
Biasakan membersihkan toilet seminggu sekali, tempat ini sangat rentang bakteri dan kuman.
Gosok setiap permukaan kamar mandi secara menyeluruh, terutama di bagian yang penuh noda, toilet bersih kunci dari hidup yang sehat.
Baca: Dua Hal Ini Yang Bikin Pebalap Dani Pedrosa Gagal di Podium MotoGP 2018 Ceko, Hanya Alasan Atau?
Baca: Suga BTS Grogi dan Tersipu Malu Saat Dirangkul Taylor Swift, Lihat Ekspresinya
3. Handuk
Cucilah handuk seminggu sekali, keringkan di bawah sinar matahari langsung agar bakteri dan kuman cepat mati.
Usahakan untuk mencuci handuk dengan air panas agar tak memicu perkembangbiakan bakteri di handuk.
4. Bantal
Tungau bisa berkembang biak di dalam bantal, terlebih bila kamu malas menggantinya bisa menyebabkan alergi.
Sebaiknya cuci bantal atau jemur setiap satu minggu sekali, usahakan untuk mengganti sarung bantal 2 hari sekali.
Baca: Mundur, Jadwal Rekrutmen CPNS 2018, Pendaftaran, Berkas Dan Tes
Baca: Menikah dengan Pria Biasa, Putri Jepang Ayako Tak Boleh Tinggal di Istana, Mengharukan
5. Kulkas
Usahakan untuk melap seluruh interior kulkas, pada bagian dalam maupun bagian luar kulkas setiap seminggu sekali dengan menggunakan cuka.
Cara ini bisa membuat kulkas kesayanganmu bebas dari kuman dan bakteri.
Meski terdengar spele, namun langkah ini bisa mencegah datangnya penyakit. (*)